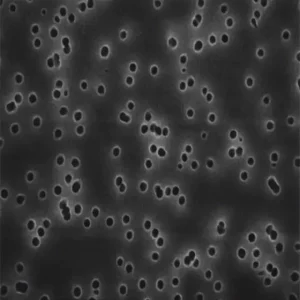
GTTP02500 美国密理博Millipore Isopore滤膜 / 聚碳酸酯膜过滤器

品牌介绍
密理博Millipore®
我们理解,在将产品推向市场时,安全性、可靠性、一致性和合规性对您而言至关重要。
这就是Merck品牌Millipore®提供行业领先产品和服务生态系统的原因,该系统涵盖制备、分离、过滤和监测各个方面 — 所有这些都深深根植于质量、可靠性和经过时间考验的流程。
实验室滤膜(又称切割圆盘滤膜)与过滤器支架和其他硬件一起用于各种应用,包括预过滤、溶剂过滤、样品澄清、消毒过滤、空气监测、颗粒收集和分析以及其他生物和环境应用。

Millipore® 产品系列
- 细胞培养样品的制备
- 色谱样品的制备
- 蛋白质样品的制备
- 蛋白质检测及量化
- 实验室规模过滤器
- 微生物测试和监测
- 大规模无菌过滤
- 下游处理
- 一次性产品生产
未找到您需要的产品?
很乐于为您寻找或定制最合适的采购方案。